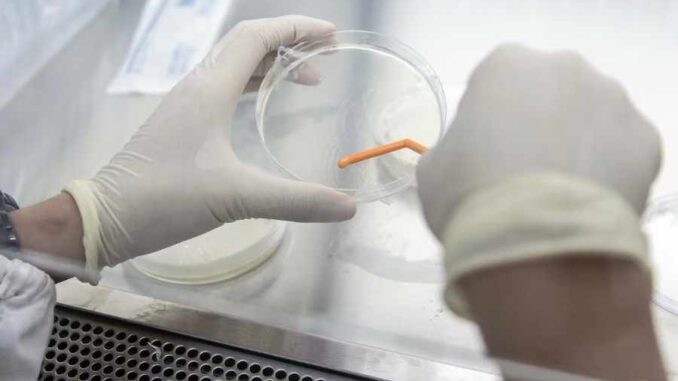

Los pacientes de la ‘enfermedad X’ en el Congo reportaron síntomas como fiebre, tos y secreción nasal.
Los científicos que compiten contra el tiempo para contener un brote de una misteriosa enfermedad similar a la gripe en una zona remota de la República Democrática del Congo tienen más que enfrentar que identificar su causa.
Para llegar al epicentro del brote de la “Enfermedad X” se necesitan aproximadamente 48 horas desde la capital, Kinshasa.
Además, allí es la temporada de lluvias, lo que ralentiza el avance de los expertos, así como los equipos de prueba y otros suministros médicos a la zona de la provincia de Kwango, en el suroeste del país, una zona boscosa.
Los funcionarios de la Organización Mundial de la Salud (OMS) enfatizaron los desafíos a medida que surgen más casos de la enfermedad no identificada, caracterizada por fiebre, tos, secreción nasal y dolores.
Suman más de 400 casos de la ‘enfermedad X’
“El acceso por carretera es difícil y la red de comunicaciones es limitada”, dijo la agencia en un comunicado.
La organización, junto con el Instituto Nacional de Salud Pública del Congo y los Centros Africanos para el Control y la Prevención de Enfermedades, han enviado equipos a la región.
Desde finales de octubre se han registrado más de 400 casos de esta enfermedad no identificada, y las autoridades nacionales fueron alertadas del brote el 1 de diciembre.
Desde finales de octubre se han registrado más de 400 casos de esta enfermedad no identificada, y las autoridades nacionales fueron alertadas del brote el 1 de diciembre.
La mayoría de los casos se dan en niños menores de cinco años y surgieron en un momento de mayor circulación de la gripe.
Por ahora, la neumonía aguda, la gripe, la COVID-19, el sarampión y la malaria se consideran posibles factores causales, indicó la agencia de salud de las Naciones Unidas. En esta etapa, también es posible que más de una enfermedad esté contribuyendo a los casos y muertes.
El Congo, que es tan grande como los estados de Alaska y Texas en Estados Unidos juntos, alberga el 10 por ciento de los bosques tropicales del mundo y es donde se identificó el ébola en la década de 1970.
La mayor interacción entre humanos y animales ha provocado la propagación de otras enfermedades a las personas a través de roedores y murciélagos infectados en la región.
Las guerras y las crisis climáticas han debilitado los sistemas y las infraestructuras de salud, lo que ha agravado la carga de la malaria, el mpox y los virus hemorrágicos como el ébola, y ha dejado a decenas de millones de congoleños al borde de la inanición.
Se informa de que todos aquellos que presentan los síntomas más graves de la “enfermedad X” sufren desnutrición grave.
Las dificultades ponen de relieve la necesidad de reforzar las capacidades de vigilancia y de laboratorio en la región, afirmó Jean Kaseya, director del CDC de África, en un comunicado.
Aun así, los desafíos también significan que los científicos de la región están bien versados en el abordaje de enfermedades infecciosas con recursos limitados.
El Financiero
